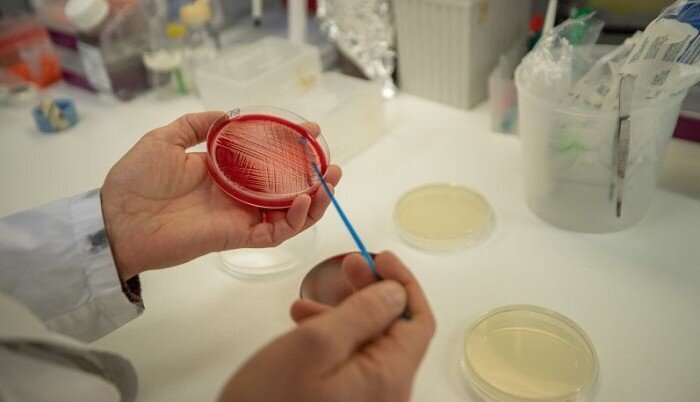
Stafylokokk, Universitetet i Tromsø Bildet viser hender og en petriskål.

Oppdaget en helt ny stafylokokk
Kan være første gang en ny stafylokokkart er oppdaget i Norge.
Den nye typen har fått navnet staphylococcus borealis, siden den er oppdaget i nord og kan være tilpasset et nordlig klima.
Det er forskning.no som forteller om oppdagelsen, som er gjort på Universitetet i Tromsø.
Studerte hudbakterier
Stafylokokker er en del av menneskers normalflora, men kan også være årsak til infeksjoner. Sykepleiere er godt kjent med den gule stafylokokken, som er en hyppig årsak til blant annet sårinfeksjoner på sykehus. Dens egentlige navn er staphylococcus aureus.
Oppdagerne tror foreløpig at den nye stafylokokken, staphylococcus borealis, tilhører vår normalflora, og vet ikke hva slags sykdom den eventuelt kan gi.
De fant bakterien da de studerte hudbakterier som kan føre til alvorlige infeksjoner, særlig hos premature.
Ikke vanlig
Grundige DNA-analyser førte til oppdagelsen av bakterien, og ifølge forskning.no er det ikke ofte det oppdages nye bakterier.
– Jeg tror ikke det har vært oppdaget en ny stafylokokkart i Norge noen gang, sier Pauline Cavanagh, en av forskerne bak oppdagelsen, til forskning.no.
Vil du vite mer om stafylokokker? Ta quiz: Hva vet du om stafylokokker?









0 Kommentarer